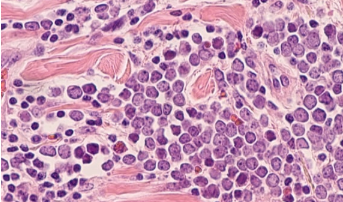
ALX Oncology在HNSCC研究中将主要资产与Keytruda配对 中网时尚,stylechina.com

ALX肿瘤将与制药巨伙伴默克到评价的组合其CD47抑制剂Keytruda作为用于患者头颈鳞状细胞癌(HNSCC)的潜在治疗。
总部位于加利福尼亚的ALX将启动一项II期研究,该研究包括HNSCC的多项试验。第一个计划将评估ALX148,这是一种研究性的下一代CD47阻断剂,与默克公司的检查点抑制剂相结合,可作为表达转移性或不可切除的HNSCC的PD-L1患者的潜在一线治疗。第二项研究将评估ALX148联合Keytruda和标准化学疗法在一线治疗转移性或不可切除的复发性HNSCC患者的疗效。
II期计划遵循在该适应症中ALX148和Keytruda的Ib期研究中看到的有希望的数据。这是这项研究的基础,为二月份美国食品和药物管理局为该适应症授予快速通道名称铺平了道路。在6月的美国临床肿瘤学会虚拟会议上介绍了Ib期结果。数据显示,已经接受过先前的铂类治疗进展且从未接受过用ALX148与派姆单抗联合治疗的检查点抑制剂的HNSCC患者表现出40%的客观缓解率(ORR)。此外,数据显示患者获得了4.6个月的中位无进展生存期(PFS)。未达到中位总体生存期(OS)。
ALX148将高亲和力CD47结合结构域与灭活的专有Fc结构域结合在一起。ALX148与多种领先的抗癌药物结合使用,已在各种血液和实体恶性肿瘤中表现出令人鼓舞的临床反应。
ALX肿瘤学总裁兼首席执行官Jaume Pons说,与默克的合作建立在Ib期研究中所见的“引人注目的联合活动”的基础上。
“ ALX148设计与多种抗癌药联合使用以最大化临床活性。我们相信,阻断CD47髓样检查点途径可以桥接针对癌症的先天性和适应性免疫反应,从而提高疗效。”庞斯在公司中也说。“我们的目标是通过开发ALX148作为基础检查点免疫疗法来改变癌症患者的治疗选择。”
默克(Merck)的Keytruda 于2019年被批准为转移性或不可切除的复发性HNSCC患者的单一疗法一线治疗。该批准将Keytruda标记为在肿瘤表达PD-L1或与化学疗法联合使用的患者(无论PD-L1表达如何)的转移性或不可切除,复发性患者中,单线疗法被批准用于一线治疗的第一抗PD-1治疗HNSCC和首个抗PD-1治疗方法在这些患者的OS中显示出统计学上的显着改善。Keytruda最初于2016年获准用于治疗复发或转移性HNSCC且疾病进展在含铂化疗期间或之后的患者。
ALX Oncology并非本月唯一与默克在HNSCC合作的公司。位于纽约的Vaccinex,Inc.宣布将于9月16日将其研究用的SEMA4D抑制剂pepinemab与Keytruda配对使用。Pepinemab,也称为VX15 / 2503,是一种人源化单克隆抗体,可结合并阻断semaphorin 4D(SEMA4D)的活性,后者是一种调节免疫和炎性细胞迁移和功能的细胞外信号分子。
ALX Oncology打算将ALX148推进临床开发,以治疗骨髓增生异常综合症,并继续进行临床开发,以治疗一系列实体瘤适应症。